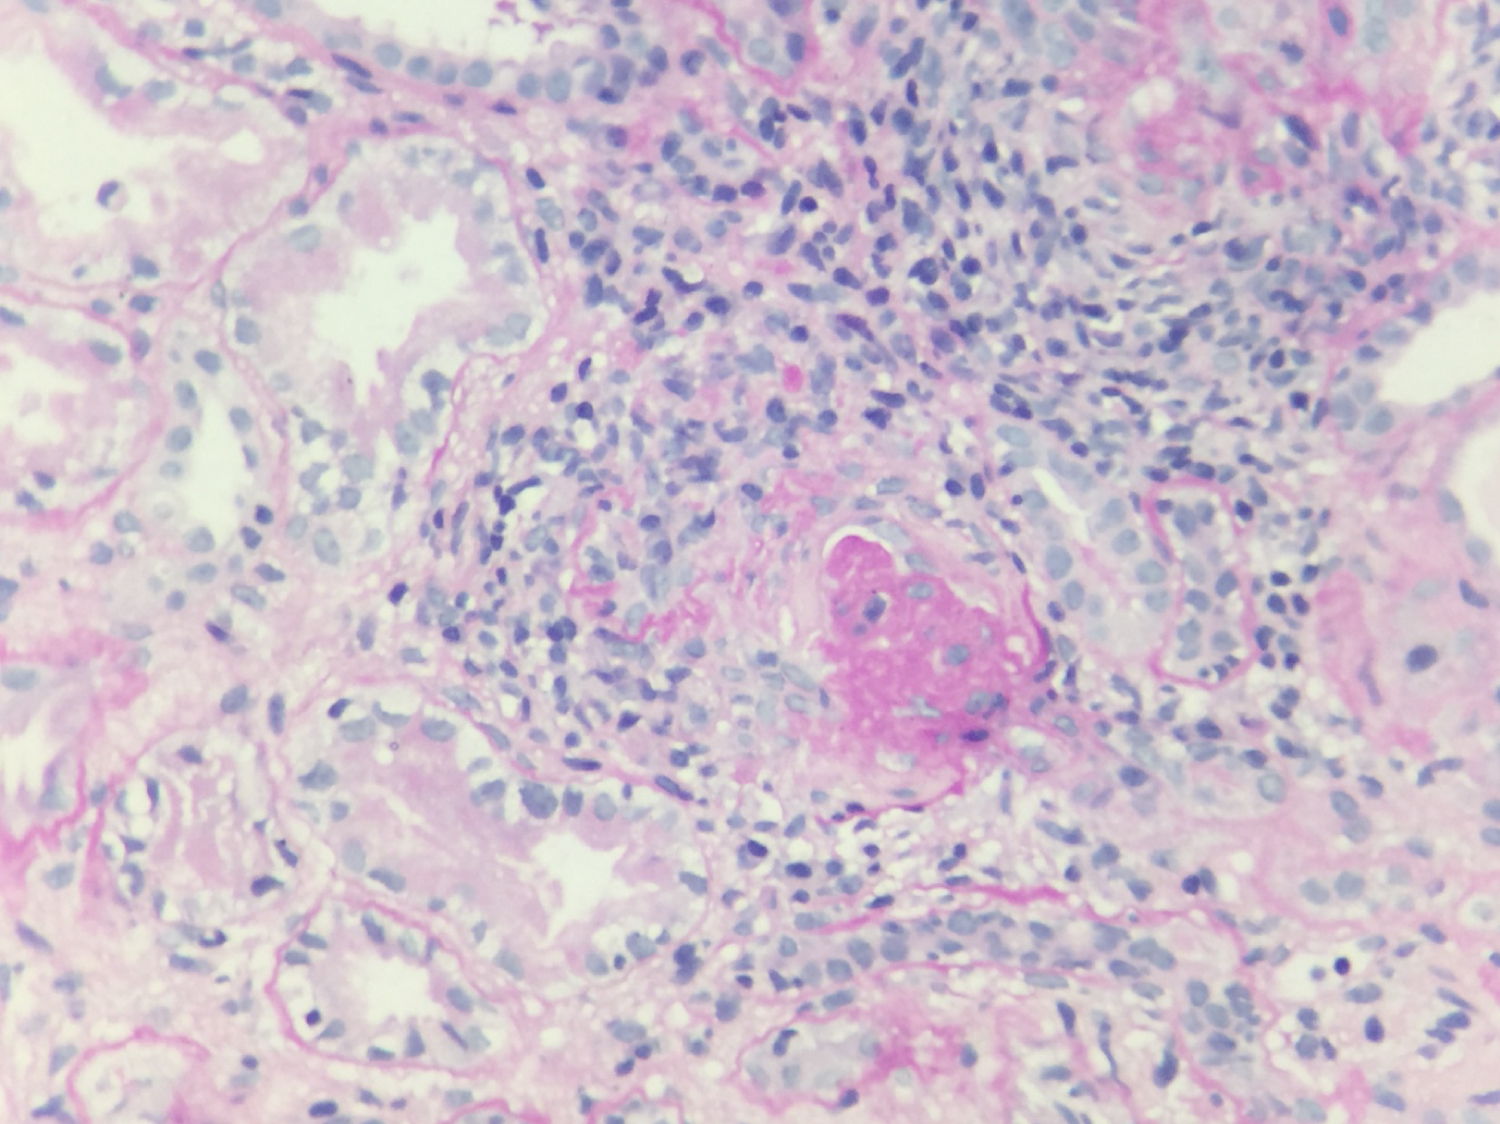

The recognition of autoimmune manifestations during the course of an infection and the decision to add specific treatment for the secondary immunological abnormality are essential decisions which have to be taken timely. Mycobacterium tuberculosis infection is a common presentation in tropical countries. The kidney is generally involved due to haematogenous spread of infection from the primary source. Glomerular involvement presenting as a rapidly progressive glomerulonephritis (RPGN), is extremely rare. We report a case of a 65-year-old female with generalized lymph node mass, with acid fast bacilli (AFB) positivity, presenting with rapidly progressive glomerulonephritis. On evaluation, antineutrophil cytoplasmic antibody (p-ANCA) positivity was found. She was successfully treated with haemodialysis support, plasmapheresis, Injection Methylprednisolone and anti-tubercular therapy.
Mycobacterium tuberculosis, Acid fast bacilli (AFB), Rapidly progressive glomerulonephritis, Antineutrophil cytoplasmic antibody (p-ANCA), Pauci-immune disease
Necrotizing crescentic glomerulonephritis is a nephrological emergency commonly presenting as rapidly progressive renal failure. Renal limited crescentic glomerulonephritis is a small subset of such patients which may or may not be ANCA positive. The presence of simultaneous active infection in the presence of ANCA mediated crescentic glomerulonephritis is rare and constitutes a thereupatic challenge [1,2]. We describe a case of Tubercular Lymphadenitis with ANCA positive crescentic glomerulonephritis presenting simultaneously which was successfully managed with a good clinical outcome [1,2].
A 65-year-old lady presented with history of fever of three weeks duration and gradually developed puffiness of face and limbs, since a week. She had reduced appetite and decreasing urine output since one week as well. Fever was moderate grade; not associated with any chills, rigors or showed any diurnal variation. There was no history of cough, breathlessness, haemoptysis, skin rash, joint pains, mouth ulcers, pain abdomen, haemeturia, ocular complaints. On clinical evaluation, she had oedema, temperature of 101 deg F, BP was 160/90 mm of Hg. Right arm was supine. She had a two cm firm and on tender lymph node palpable in the right axillary region of the medial group. Systemic examination was unremarkable. Initial investigations revealed Hb 10.4 gm/dl, TLC: 12,200/cumm, DLC: (Neutrophils 79%, Lymphocytes 18%, Monocytes 2% and Eosinophils 1%), Platelets 4, 00,000 per cubic mm, ESR: 68 mm, CRP: 9.0 mg/L, BUN 30 mg/dl, serum creatinine of 2.4 mg/dl. Urine showed numerous dysmorphic RBCs per high power field, and urine dipstick showed 2+ proteins. Twenty four hour urinary protein excretion was 1.3 gm per day. She had rapidly worsening renal function with reduced urine output and her serum creatinine increased to 5.8 mg/dl over the next one week. Ultrasound of the abdomen revealed multiple retroperitoneal Lymph Nodes along with mesenteric lymph nodes forming a lymph node mass. The size of the lymph node mass was 2.2 × 1.7 cm. Her sputum for both acid fast bacilli (AFB) and Gene expert for Mycobacterium tuberculosis was negative. A non-contrast CT scan of the chest and abdomen revealed multiple lymph nodes; Preaotric, Paraortic, Precaval and Peripancreatic region, along with mesenteric lymph nodes forming a lymph node mass with size of 2.2 × 1.9 cm. Her kidney size was 10.9 × 4.1 cm (Rt) and 10.4 × 4.2 cm (Lt) with increased echogenecity and preserved corticomedullary differentiation. Culture from the Fine needle aspiration cytology (FNAC) of the lymph node revealed acid fast bacilli, which was MTB gene Xpert positive. The histopathology from the CT guided biopsy of the axillary lymph node revealed wide areas of caseation necrosis and numerous epitheloid granulomas, along with few giant Langerhan cells. Her immunological investigations revealed p-ANCA positive (Immune florescence assay 1:40), c-ANCA was negative; and anti-MPO, anti-PR3 antibody titres by ELISA, were within normal range, Antinuclear antibody (ANA), Double stranded DNA (DsDNA), Anti-phospholipid antibody (APLA), anti cardiolipin antibody, lupus anticoagulant, beta2 glycoprotein was negative, HBs Ag was negative, HCVRNA was undetectable, HIV was non reactive. Further, the C3, C4 levels were normal, anti GBM antibody, serum cryoglobulins negative, urine AFB was negative, urine MTB PCR was negative as well. She further underwent special investigations in the form of anti-lactoferrin antibodies, which was found to be positive. The patient was initiated on haemodialysis due to rapidly worsening renal function. She underwent renal biopsy which on Light Microscopy revealed fourteen glomeruli; with one glomerulus with global sclerosis, six glomeruli with circumferential cellular crescents accompanied by fibrinoid necrosis in four capillary tufts, the capillary tufts were partially obliterated and filled with neutrophils; the capillary membranes were thickened and duplicated and the Bowman's capsule was thickened. There were no Langerhan cells in the kidney, tubules were moderately degenerated and focally atrophied, and the interstitium had focal oedema and leucocyte infiltration, arterioles revealed mild hyalinosis and there were no features to suggest any thrombotic microangiopathy. Immune fluorescence was negative for all antibodies, complements and fibrinogen were negative. Congo red stain for amyloid was negative, suggestive of necrotizing crescentic glomerulonephritis (GN). Electron microscopy revealed disruption of the glomerular basement membrane, subendothelial oedema, microthrombosis and no immune deposits.
She was managed as a case of Tubercular Lymphadentits with ANCA mediated focal necrotising crescentic glomerulonephritis. She received alternate days of plasmapheresis with 0.4 L/Kg of plasma removed in each session, for a total duration of five sessions and Inj Methyl prednisolone of 500 mg for three days followed by oral prednisolone at 01 mg per kg body weight. Anti-tubercular therapy in the form of cap Rifampicin, Tab Isoniazid, Tab Ethambutol and Tab Pyrazinamide was initiated after her plasmapheresis sessions were finished. She was also treated with low monthly dose of injection Cyclophosphomide of 500 mg IV. There was rapid improvement in her clinical condition and urine output as a result of this regime. After two weeks post-initiation of plasmapheresis, her serum creatinine settled to 1.9 mg/dl. Her steroids were rapidly tapered in view of her active tuberculosis and low dose Inj Cyclophosphamide 500 mg IV, was continued every 02 weeks for three months; followed by maintenance therapy with tablet Azathiopyrine at 01.5 mg/Kg body weight. She had good response to her antitubercular regime and a repeat CT of the chest and abdomen at two months, revealed marked resolution of her lymph nodes in the retroperitoneal region and was shifted to the three drug maintenance regime and her Tab Pyrazinamide was stopped. At six months, follow up p-ANCA returned negative. She was continued on anti-tubercular therapy for nine months. She received maintenance therapy for her necrotic crescentic glomerulonephritis with Tab Azathiopyrine for a period of 24 months. Presently she is on regular follow-up and maintaining stable creatinine of 1.7 mg/dl with resolution of her Tubercular Lymphadenitis (Figure 1, Figure 2, Figure 3 and Figure 4).
Figure 1: PAS stain high power view: Glomerulus with crescent.
View Figure 1
Figure 1: PAS stain high power view: Glomerulus with crescent.
View Figure 1
 Figure 2: Haematoxyline and Eosin (H&E) stain (low power view) effaced lymph node architecture with caseation necrosis.
View Figure 2
Figure 2: Haematoxyline and Eosin (H&E) stain (low power view) effaced lymph node architecture with caseation necrosis.
View Figure 2
 Figure 3: Haematoxyline and Eosin (H&E) stain: Langerhan giant cells with caseation necrosis.
View Figure 3
Figure 3: Haematoxyline and Eosin (H&E) stain: Langerhan giant cells with caseation necrosis.
View Figure 3
 Figure 4: ZN stain showing acid fast bacilli.
View Figure 4
Figure 4: ZN stain showing acid fast bacilli.
View Figure 4
Infections can lead to antibody formation like rheumatoid factor, antinuclear antibodies (ANAs), anti-phospholipid antibodies, and anti-neutrophil cytoplasmic antibodies (ANCAs). The recognition of autoimmune manifestations during the course of an infection and the decision to add specific treatment for the secondary immunological abnormality, are essential decisions which have to be taken timely [1]. The kidneys are one of the common organs affected by either the primary infectious process or secondary immunological disease. Infection related glomerulonephritis due to immune complex deposition in glomeruli, through either in situ formation or trapping of circulating immune complexes [3], is quite common; while ANCA associated glomerulonephritis in the presence of active infection is rare [1,3]. The presence of ANCA in the systemic circulation can have varied etiologies; from drugs, infections, neoplasias and non infectious inflammatory conditions. The kidneys are one of the main organs affected by ANCA-associated disease. There are scant reports of histological proven glomerulonephritis and ANCA positivity, during the course of an infectious episode. Of the fifty cases reported in literature, more than half are in patients with infective endocarditis, predominantly presenting as immune complex mediated glomerulonephritis. The microbiological diagnosis in two thirds of the cases, are from gram positive cocci, like Staphylococci, Streptococci and Enterococcus species; while Mycobacterium tuberculosis infection has been rarely reported [1]. Tuberculosis itself can cause renal disease in a number of ways. The most common form is direct haematogenous spread [4,5]. Chronic interstitial nephritis and amyloidosis are some other forms of involvement with histopathology revealing epitheloid granulomas, Langerhan cells with or without caseation [6]. Moreover, the presence of ANCA in pulmonary tuberculosis patients has also been reported by Pradhan, et al. to be 30%, with 52% of those patients having p-ANCA pattern on immune fluorescence, and clinical relevance has been given only to anti PR3 [4].
Out of the 17 cases of glomerulonephritis associated with Tuberculosis reported in literature [7-9]; six were associated with IgA nephropathy [10,11], four were crescents [12], two were mesangial proliferative [13-15], two were membranous nephropathy [16]; and one each of mesangiocapillary and collapsing glomerulopathy [16].
Our patient had a subacute presentation, with fever, malaise and significant weight loss; and on clinical evaluation, had multiple lymph nodes, which revealed caseation necrosis and grew acid fast bacilli, with positive gene Xpert. The ANCA positivity was of p-ANCA by immune fluorescence with titres of 1:40; ELISA titres of anti-PR3 and anti-MPO were negative; while anti-lactoferrin antibodies were positive. The renal failure in our patient had already set in before initiation of anti-tubercular therapy; and the patient was not on any other drugs which could have led to ANCA positivity. The therapeutic dilemma was to consider the pathogenesis of this ANCA positivity and if treated with immune suppression, the extent of the flare of Tuberculosis. The presence of necrotizing focal crescentic glomerulonephritis progressing to dialysis dependent renal failure; and no immune deposits with normal complement levels; entailed us to treat our patient as ANCA-mediated glomerulonephritis. We initiated treatment with plasmapheresis, Injection Methylprednisolone, followed by Inj Cyclophosphamide, while rapidly tapering her steroids and anti-tubercular therapy and initiated antitubercular therapy after her plasmapheresis sessions had finished. After three months of bimonthly Injection Cyclophosphamide, we shifted her to maintenance therapy of Azathiopyrine. Her lymph nodes showed regression; and she was treated with her full course of antitubercular therapy for a period of nine months. After 24 months of therapy, she is maintaining a stable renal function of 1.7 mg/dl. This case is clinically relevant, as pauci-immune glomerulonephritis with active extrapulmonary tuberculosis, is extremely rare. Moreover the pathogenesis of ANCA was of the perinuclear pattern, not anti-PR3 as reported by Pradhan, et al. [4].
There are diagnostic challenges in treating these patients. Firstly, there is similarity of the clinical manifestations between the two categories of diseases; whether it is vasculitis, or a chronic infection, like Tuberculosis. Malaise, weakness, fever, anorexia, weight loss, arthralgia and myalgia, are cardinal manifestations of both disease categories; as are several laboratory findings including anemia, leucocytosis and thrombocytopenia. The second major diagnostic difficulty is that patients with severe or complicated infections, often develop multiple auto antibodies which can be associated with specific renal diseases like ANCA, anti-nuclear antibodies, anti-phospholipid antibodies, anti-glomerular basement membrane antibodies and cryoglobulins [1].
There are meaningful learning points for clinicians managing such cases. Firstly; given the high frequency of renal involvement during serious infectious episodes and the variety of renal pathologies that can be seen in patients with infections; renal function should be monitored with frequent urine examinations and measurements of serum creatinine concentration. If renal involvement is diagnosed; kidney biopsy with complete histological evaluation by light microscopy, immune fluorescence and electron microscopy, should be performed in a timely manner to come to a definitive conclusion. Secondly; the pathogenecity of ANCA in the presence of infection can be ascertained on a case basis; if organ threatening damage is evident, the treatment would entail treatment of the ANCA vasculitis in a guarded manner, along with treatment of the active infection. It is prudent to expand testing for other antibodies like Lactoferrin, cathepsin, elastase and anti-Lamp in cases where anti-MPO and anti-PR3 are negative.
In the present case Necrotizing Crescentic Glomerulonephritis has been confirmed by renal biopsy, while the lymph node biopsy demonstrated the granulomatous lymphadenitis, along with caseation necrosis and the giant Langerhan cells infiltration. There was a delimma for the therapy, because ANCA-associated GN treated with immune suppression may lead to the flare of Tuberculosis. However, the patient has been successfully managed with a good clinical outcome.
In conclusion, ANCA mediated necrotizing crescentic glomerulonephritis (NCGN), is an extremely rare presentation with Tuberculosis. It requires timely diagnosis and prompt initiation of therapy, for both the ANCA mediated disease and the active infection. A guarded and timely approach can often lead to a favourable outcome. It should therefore be suspected in rapidly developing renal failure in the presence of Tuberculosis and be aggressively managed.